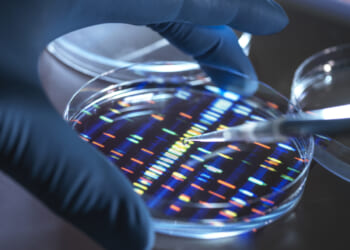
Is engineering a ‘super’ human being a good idea?

British engineering firm helping to keep astronauts safe on first manned Moon mission in 50 years
A British engineering firm has played a key role in the first manned moon venture in half a century.John Crane, which established its headquarters in Slough, Berkshire in 1923, has developed and produced specialist components…